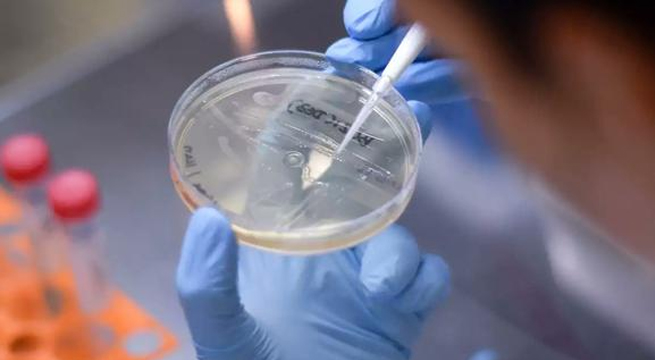
OMS: La variante Delta del Covid-19 se está volviendo la dominante en el mundo

Representante del Minsa mencionó que esto será posible en la medida que el actual ritmo de vacunación continúe durante el próximo gobierno.

La científica jefa de la organización lamentó la poca efectividad de la medicina contra el Covid-19

El ministro de salud recordó que este sábado 19 de junio se iniciará la vacunación de las personas que padecen de cáncer y de VIH en Lima Metropolitana y Callao
La científica jefe de la organización hizo hincapié en la mayor transmisibilidad de la variante hallada en la India

Las provincias de Lima Metropolitana y el Callao bajarán su nivel de riesgo de muy alto a alto

Perú superó los dos millones de casos positivos desde el inicio de la pandemia y es el país con mayor tasa de muertes

La medicina desarrollada en Alemania solo alcanzó una eficacia de 47% contra el Covid-19

Esta cepa del virus, encontrada inicialmente en la India, es más transmisible y genera mayor riesgo de hospitalización

El descenso en los niveles de contagio ha hecho que el nivel de riesgo deje de ser muy alto

A pesar de que la pandemia aún no ha terminado, muchos irresponsables continúan violando las restricciones durante los fines de semana